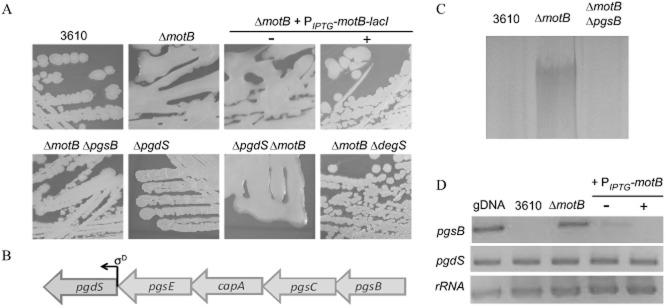
https://cdn.ncbi.nlm.nih.gov/pmc/blobs/a2c8/3963450/ef4482d24607/mmi0090-0006-f1.jpg
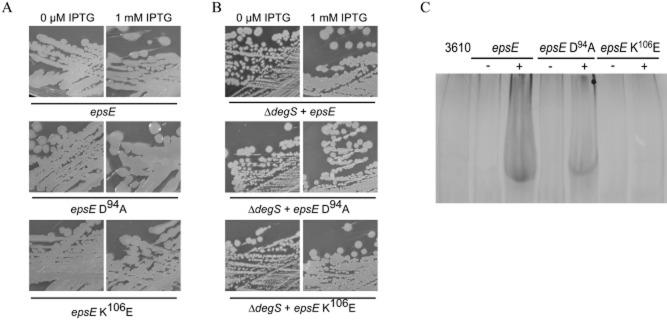
https://cdn.ncbi.nlm.nih.gov/pmc/blobs/a2c8/3963450/b6baaad20b79/mmi0090-0006-f6.jpg

鞭毛传递的机械信号控制枯草芽孢杆菌中的信号转导。
A mechanical signal transmitted by the flagellum controls signalling in Bacillus subtilis.
机构信息
Division of Molecular Microbiology, College of Life Sciences, University of Dundee, Dundee, DD1 5EH, UK.
出版信息
Mol Microbiol. 2013 Oct;90(1):6-21. doi: 10.1111/mmi.12342. Epub 2013 Aug 14.
In the natural environment bacteria predominantly live adhered to a surface as part of a biofilm. While many of the components needed for biofilm assembly are known, the mechanism by which microbes sense and respond to contact with a surface is poorly understood. Bacillus subtilis is a Gram-positive model for biofilm formation. The DegS-DegU two-component system controls several multicellular behaviours in B. subtilis, including biofilm formation. Here we identify the B. subtilis flagellum as a mechanosensor that activates the DegS-DegU regulatory pathway. Inhibition of flagellar rotation by deletion or mutation of the flagellar stator gene, motB, results in an increase in both degU transcription and DegU∼P driven processes, namely exoprotease production and poly-γ-dl-glutamic acid biosynthesis. Similarly, inhibition of flagellar rotation by engaging the flagellar clutch or by tethering the flagella with antibodies also promotes an increase in degU transcription that is reflective of increased DegU∼P levels in the cell. Collectively, these findings strongly indicate that inhibition of flagellar rotation acts as a mechanical trigger to activate the DegS-DegU two-component signal transduction system. We postulate that inhibition of flagellar rotation could function as a mechanical trigger to activate bacterial signal transduction cascades in many motile bacteria upon contact with a surface.
在自然环境中,细菌主要以生物膜的形式附着在表面上生存。虽然已经了解了生物膜组装所需的许多成分,但微生物如何感知并响应与表面接触的机制仍知之甚少。枯草芽孢杆菌是生物膜形成的革兰氏阳性模式生物。DegS-DegU 双组分系统控制枯草芽孢杆菌中的几种多细胞行为,包括生物膜形成。在这里,我们确定枯草芽孢杆菌的鞭毛是一种机械感受器,它可以激活 DegS-DegU 调节途径。通过缺失或突变鞭毛定子基因 motB 抑制鞭毛旋转,会导致 degU 转录和 DegU∼P 驱动的过程(即外蛋白酶产生和聚-γ-dl-谷氨酸生物合成)增加。同样,通过接合鞭毛离合器或用抗体固定鞭毛来抑制鞭毛旋转,也会促进 degU 转录的增加,这反映出细胞中 DegU∼P 水平的增加。总的来说,这些发现强烈表明抑制鞭毛旋转可以作为一种机械触发,激活 DegS-DegU 双组分信号转导系统。我们推测,在与表面接触时,抑制鞭毛旋转可以作为一种机械触发,激活许多运动细菌中的细菌信号转导级联反应。